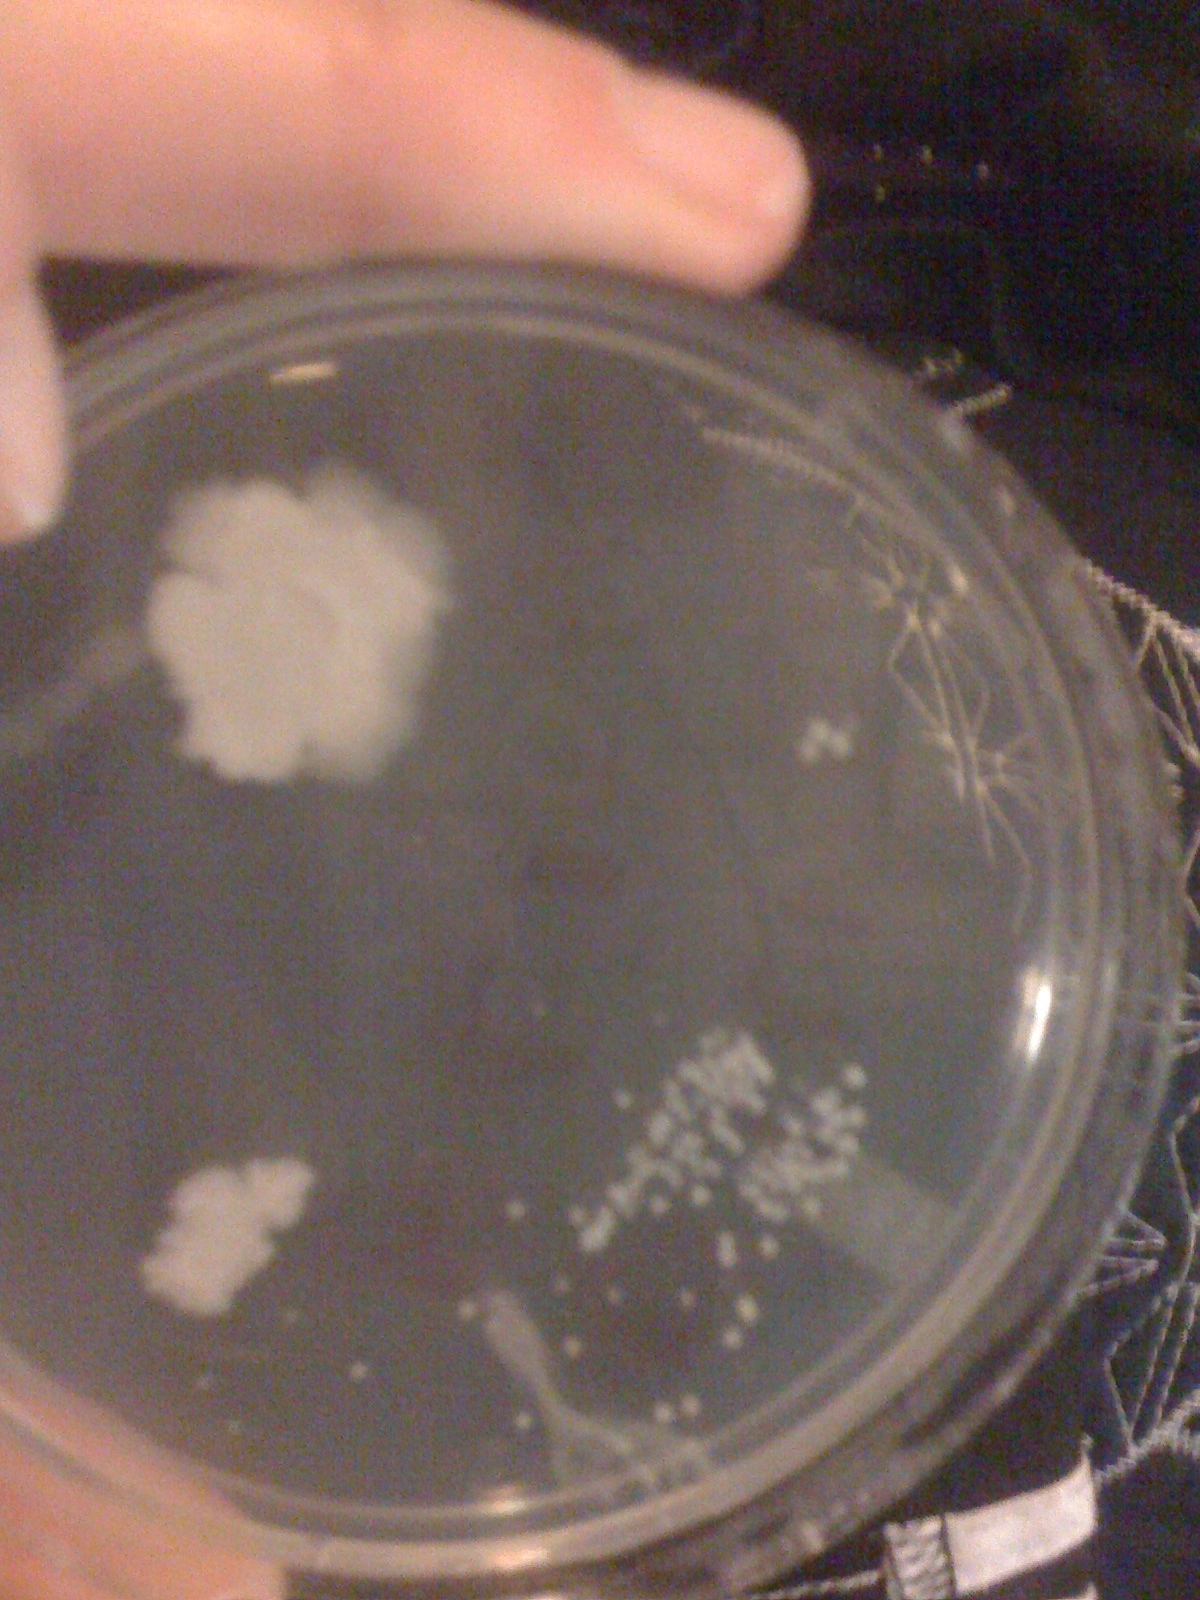

In a word, yes.
And this is a difficult concept for many doctors to get because we have long been taught that the gold standard is culture.
Let’s back up a little. These are the symptoms of a bladder infection:
- needing to empty your bladder a lot (urinary frequency)
- when you gotta go, you gotta go (urgency)
- pain just over the pubic bone
- blood in the urine
- burning when you empty your bladder, some women say it’s like peeing razor blades (dysuria)
If you have any one of these symptoms of a bladder infection there is a 50% chance you have one. If you have both burning when you pee (dysuria) and need to go a lot (frequency) and don’t have vaginal discharge or vaginal irritation there is a 90% chance you have a bladder infection.
So with this information in mind, if your symptoms are classic there’s a pretty good chance you have a bladder infection and you may get treated over the phone without a culture. However, if your symptoms aren’t classic or you have been suffering from recurrent infections your doctor should do a culture, meaning have the lab try to grow bacteria from your urine. Another advantages to growing the bacteria are to confirm you are on the right antibiotic.
So what if the urine culture is negative, but you or your doctor are convinced your symptoms are a bladder infection?
Urine cultures report the amount of bacteria in the urine, and usually only report 100,000 colonies (groups) of bacteria per ml of urine (see this clip if you want to see how it’s actually done) or more. Many labs report 10,000 colonies of bacteria/ml of urine or less as negative although some use 50,000 colonies/ml as their negative cut off. The problem? At least 30% of adult women with a bladder infection will have 10,000 or fewer colonies/ml.
So….what’s a girl who thinks she has a bladder infection to do?
If your symptoms are not so classic, most doctor’s will get a microscopy test (look at the urine under the microscope) while waiting for the culture. The microscopy test is about 87% accurate, meaning it will still miss some infections.
But there may be a situation where your or your doctor are pretty convinced you have a bladder infection (either based on your symptoms or the microscopy) and then the urine culture is read out at negative. On the assumption that you could be one of those women who gets an infection with 10,000 or fewer colonies of bacteria per urine it may very well be worth treating you for a bladder infection to see if you improve. Follow-up is essential because you should be feeling almost 100% within 48 hours, so if you are not then something else may be going on.
In an adult woman a negative urine culture does not necessarily rule out a bladder infection.
;
Remember, this post does not represent direct medical advice

I went into a clinic to have a urine test done and it came back clean yet I have many stabbing pain in back abdomen and kidneys. Lab shows negative infection. Yet I am too famili a r with the symptoms. What other tests can confirm an infection or bacteria.
Went to my Doctor, took urine sample but showed only a little blood in it. I’ve had this before several times. Been hurting when urinating and pressure. Did not give me anything. So what am I to do? She did say drink plenty of water, which I am.
If no infection is present it may very well be interstitial cystitis.
I’ve had these symptoms for weeks. I tried lots of home remedies but nothing seems to work. The urine analysis came back negative so the doctor refused to prescribe anything. I don’t know what to do. I’ve even stopped drinking coffee but…nothing.
I have many of the symptoms describe above, but is anyone else’s symptoms include a tinge of blood? Mines do.
Can anyone shed any light as to what is going on as I’m worrying. Dr found blood and protein in my urine 10 weeks ago, said I had a UTI gave me a 3 days course of Trimethropin, just over a week later I went back as I didn’t feel right. 7 Days course of Nitrofuantin, since then I have had another two weeks courses of Trimethropin. Dr has scared the life out of me as she mentioned the “c” word and I have an hospital appointment in early May. She went into great detail about the procedure where they put the tube into your bladder and how painful it is. I’m sure she was enjoying telling me.
I took a urine test in at the end of my last bout of anti-biotics and was told that nitrite, blood, and leukocytes were in it so it was sent off for culture came back negative. Send one in a week later, came back all clear. However, I have been doing dip tests at home and I had days where leukocytes and trace blood are there, some days where it is all clear and this morning it has just showed ++ blood.
I am worrying myself sick and I feel very tired. My blood tests came back okay apart from MCH being slightly high at 5.17. Dr said this was OK.
Could this be just an infection that isn’t clearing? For months leading up to this I had pain each side of my back bone at the bottom of my spine, it was also very tender to touch. Dr put this down to my constipation that I always have. I have noticed however that since having all these antibiotics it’s not tender to touch anymore.
I am so worried that it’s cancer. I am 50 and gone through the menopause.
Feeling reassured I am not the only one suffering in silence. Have been feeling so uncomfortable for 12 months now. Went to the Doctor and was given antibiotics because they confirmed a UTI but within a week it had returned. Had to give another sample which proved positive but negative for the culture, so gave another sample today which again, proved positive but the doctor’s office will send it off to the lab to do a culture. The discomfort can be unbearable and I have had enough now!!! It is taking over every day life!!
Caroline, my mother is going through the exact same thing. I feel very bad, because my feeling is there is some
else going on. I feel as though, this situation warrants further testing. My mother is 90 years old. a registered nurse by her career. After a family of six children, my mom knows her stuff. She certainly knows her body. As I
am sure you do. I am at the point, were I am feeling as though I need to contact a medical advocate to help/
It is so important to to have a good relationship with your doctor. So that you can communicate effectively.
I had symptoms of UTI as well as intermittent hematuria. Although they found bacteria in the initial urinalysis, my urine culture turned out to be negative. Since I still had symptoms of UTI despite testing negative after the culture, I went to get a second opinion from a different urologist. He tested me for gardnerella and came back positive. I was treated with Metronidazole and my UTI symptoms went away. Although I had no other typical symptoms of gardnerella except for UTI symptoms, which supposedly happens although rarely, it helped rid of the discomfort I was feeling when I urinate. Hope you find this helpful and perhaps seek a second opinion.
I am 58 female had sex with my husband after about 5days went to pee and couldn’t peed before sex 2days later notice strong urnine ordor pain when I pee and pressure in lower belly now day three itching in my Virgina what’s going on. Please help
I came down with back pain that stopped me dead in my tracks it took me down the pain that was thanksgiving chills urination I finally went to a walk in doc she feared I had kidney infec I had no insurance so took the antibiotics for 7 days . No improvement went to my doc uti blood work cipro well back pain fever chills went to er I was dyhrated I got iv fluids and antibiotics pluss cipro .. I took it blood work came back 2 times neg no signs of bacteria now all I do is pee. This is so stopping life plus now it burns when I pee. Is it from the antibiotics
I’m leaving this here, on this old thread, for anyone who might be getting symptoms of a UTI but nothing develops in your urine sample. There can be other reasons, as has been discussed here. But for me, the answer was a spasm in my urethra. What helped me was drinking peppermint tea, made with fresh peppermint from my own garden, but you can easily find other sources of peppermint. Peppermint is a natural anti-spasmodic, and very potent doing the job. It helped me a lot. Whenever I get that twinge, I try the tea, and it has worked for me. I’m not in any way advising against going to the doctor if you have symptoms. But if you are coming back with no bacteria growth in the sample, this might help you.
Thanks so much for this post! I just had a UTI/bladder infection and was prescribed an antibiotic for three days. The symptoms lower down improved, but I was still exhausted, started to get chills and had lower back pain, with tenderness and swelling in the region of my kidneys. So, deciding it must have spread to my kidneys, I got a further antiobiotic – 5 days worth of cipro, from my Dad (a pharmacist). I have been feeling better now, after 2 days on that – my symptoms are going. So imagine my irritation when I phoned the doctor’s surgery to be told my results came back negative! I gave them nuclear wee, after six weeks of symptoms and clear indications of an infection which was not only present, but had spread…all I can say is these tests are not sit for purpose. What kind of condition would I have had to be in to warrant further (appropriate) treatment?
I agree with you about the tests. Mine was always negative. I am resistant to cipro now. If you get resistant to cipro, try Ceftriaxone injections. You can give it to yourself, I have learned. It is not that hard. It is a different group of antibiotics. I am on my own with kidney infections for 5 years now. The tests are always negative so I gave up on tests and just treat myself when I have symptoms.
Thanks for this, Inna. It’s good that you have found something that works!
Can you get cipro over the counter, my daughter had a test done and it came back negative, she has had a lot of bleeding and bleeding in her wee and she is itchy?
Uk doctors are very unhelpful when it comes to UTI, you can’t buy antibiotics and you must wait 3 days for results of a lab test .. Yes 3 days with burning UTI! The dipstick doesn’t pick up my infection but the laboratory always does! How annoying – especially when it gets so bad and urine clouded with blood they still have no sympathy and I have to wait drinking cranberry, taking sodium citrate and ibroprofen which helps only a little!
Have had problematic UTIs over number of years now and usually cleared with antibiotics .Many times no infection has shown in urine culture. Last 5 weeks have been a big problem ,and have left me very debilitated and nauseous,with of course frequent urination. Been given Norfloxin, Amoxycillin ,Nitrofuantin, Trimethropin and now been on Cefaclor last 2 days. Usually no infection found but as soon as a n antibiotic is started I feel so much better for awhile. Doctor rang this morning she wants me to go off Cefaclor as no infection again was found..I am so loath to do that, as had been getting steadily sicker and very nauseous few days back. Even resorted to sending a strongly worded letter to our medical Clinic . We do live in a isolated rural area here in New Zealand, and feel treatment leaves a lot to be desired,as referral to an Urologist is taking forever to come through. Am travelling to Australia in few days and am intending to get treatment there, am an Australian citizen, and hope to get some light on the trouble. My husband is very frustrated with it all, as we have a very active sex life, but so am I and of course , now so worried what might be the trouble. Even been told I might have a small kidney stone…will keep this updated.
Ooopps. This is what happened to me also, I started taking antibiotics and it had worsen the situation. You’d better go to the doctor and seek expert advice. As for me I started taking cranberries. It really helped me.
Pls help. My mother is 64 year old and complaining pain in the lower abdomen. Her urine was cultured and negative results but still the pain when urinating doesnt go away. No blood but the pain still on.
I would just start taking antibiotics. Will not hurt. If it does not work, you will go from there. But if you wait and it is an infection, then it can spread to kidneys. And that is not good.
had a stroke 2 yrs ago, about 6 months started getting tight muscles then knocked off my feet, was treated in hospital for uti which cleared ,since then have had uti symptoms urine tests keep coming back negative, yet still got symptoms of uti and my muscle tightness is getting much worse can hardly move now ,doctor insists I haven’t got infection that I have to see a urologist im in agony not convinced ,
This morning I was awoken with the worst burning feeling in a long time and needed relief right away. It was 3am so the doctor’s office wasn’t open. I dug through my sister’s medicine cabinet (I was staying at her house thank god) and found Lady Soma Cranberry Tablets. I highly recommend this product in everybody’s medicine cabinet. The product worked within 20 minutes and I was able to go back to sleep!
Please, please respond. I am so desperate. I can’t find anyone to help me.
I have had bladder infection symptoms for over 3 years. Every single culture has come back negative. I’ve been to a urologist numerous times-he tells me it is ‘getting used to intercourse’. I’ve been married 3 years now and apparently I’m still not used to intercourse because the bladder issues are still there.
I have intense low back pain, frequent urination even after drinking nothing for hours, and a crampy/dull ache where my bladder is. The back pain is horrendous and it gets very bad when the bladder symptoms are at their worst. I also have pain with intercourse which started when the bladder thing started. Also, when this started, I begun waking up at 4am, unable to go back to sleep. I am so exhausted everyday of my life.
I’m living a nightmare.
My doctor won’t give me antibiotics because the culture is negative. I can’t get in to see another urologist because my doctor has to refer me and he thinks nothing is wrong with me since I already went to one urologist.
I’m scared something is very wrong inside me. It’s gone on so long. This is the ONLY blog I’ve read that admits there could be something beyond the culture. It gives me a sliver of hope.
This response is not medical advice.
A urinary tract infection is not the only cause of needing to go to the bathroom a lot and pain with sex has many causes. Two common causes of both symptoms are pelvic floor muscle spasm and interstitial cystitis. A pelvic floor physical therapist can evaluate pelvic muscles if a doctor is not able to do that. A urologist should be able to diagnose painful bladder syndrome (PBS). This is a link with some more info on PBS http://www.examiner.com/article/understanding-painful-bladder-syndrome
I just wanted to say thank you for replying. I did read this way back but didn’t reply as I couldn’t get my doctor to refer me to anyone of these specialist. I ended up going to a naturopathic doctor who specializes with women issues. I’m not saying this is everyone’s problem … but I am 99.9% sure this is what mine was. Candida. Because after being treated and following a very specific carbohydrate diet (book name) my bladder issues are about 95% gone. As is my joint paint and mysterious rashes I used to get.
I say 95% because if I cheat for too long the symptoms somewhat come back. And now that I am pregnant, my body is more acidic, and my bladder is not liking that. The candida flares and I have to be sooo careful what I eat and drink.
Because I am not a doctor or have any right to tell people what to do, I’m ONLY saying what worked for me. And I swear by this. When I was first told candida and had not started treatment yet and my back pain was at it’s worst. I began to drink 1 tbsp of pure apple cider vinegar twice a day. Within 3-5 days the back pain vanished. I believe it has something to do with keeping your bodies PH in the right zone. Every time my back started aching I did this and every time the pain would fade away in a few days. I don’t take it at all anymore because I have no back (or bladder) pain.
I doctored for years trying to figure out why I always felt like I had a bladder infection. Dr. ruled everything out and I’ve since been diagnosed with Interstitial Cystitis/Painful Bladder Syndrome. I now take an antidepressant which has taken all the pain away! Mention it to your dr., ladies!
Heather, I posted earlier here crying about my kidney infection. I am better, knock on the wood. I got 2 different antibiotics without prescriptions and took them for over a month, one is 5-nok I( Nitroxoline) and another Furantoin. I had no choice since no doctor would help me. I was going crazy. I went on diet, no spicy food, no fried food, no salty food and no rich foods. Basically plant based, easy to digest diet. I feel alive again. I have been married for 12 years but sometimes I get kidney infection after having sex so we do not do it anymore. Believe or not, my husband have seen me suffering and he does not want me to be sick again. I just have no choice, no sex for me. Actually when I am sick, I have no sex drive anyways.
Bottom line, read online what antibiotics are good for bladder infection. Also sounds like you are developing kidney infection as well. Get on antibiotics ASAP. If you are in US, you can get them online through Canadian pharmacy without prescription. I got mine from Europe, a friend of mine brought it for me. Also after sex, you have to urinate. This way you wash the bacteria out of your urethra. Read online, there is tons of info. I have educated myself on this subject. Also you cannot have alcohol or coffee, or an caffeinated drinks at all, forever and ever. It will make your condition worse. One more, get Uva Ursi, it is an herb. Make a tea and drink it. Also chew on leaves throughout the day. It kills bacteria.
Good luck. Keep me posted. I hope you will get better.
Glad you got help. I too suffer from uti’s and almost died from kidney infection when I was 19. I went in to doc for painful urination. Culture done was negative so no antibiotics for me until I was almost dead. I recently got another uti. I’m 44 I know what they feel like and went to doc. He gave me antibiotics for 3 days I felt better culture was negative. Following month peeing blood and called doc he gave me 3 days Cipro and I took and went to see him on a Monday and culture done again negative and he was quite nasty about it too and all but accused me of lying about symptoms but he had already given me 7 days worth of antibiotics that I had started to take. I took them all and it’s a year later no reoccurrence. I have new doc can’t deal with someone who doesn’t believe me.
I would like to let you know that you are not the only one. I have recurrent uti’s-honeymoon cystitis often after sex. Four women in my family have the exact same problem. We go to the doctor because we know we have a Uti, but their tests usually show negative. They usually give me antibiotics anyway. Amazingly, every time I use the antibiotics, all symptoms go away. At one point I started having significant back pain that I suspected was a kidney infection. I went to the Dr. and she said the culture was negative and said something to the effect of, “Well, honey, you’re not twenty anymore. Sometimes you get back pain as you get older.” She basically told me to suck it up. So, I went home and sat in the floor and cried because I thought my career was going to be foreshortened due to back problems. So, a little while later I went to urgent care for uti and they treated me with antibiotics which I took religiously and . . . amazingly, all my back problems miraculously went 100% away. My back felt like I was 20 again. So, all of my back problems was a kidney infection that they could not diagnose with their little machines. This has happened a couple of times now. Repeatedly I have used the AZO home tests which turn purple indicative of infection then go to the Dr. and there test is negative. There machines are not accurate enough. I currently have a kidney infection (I know because of the exact same back pain) and I went to the Dr. today who discovered I had a fever of 99.7, yet my urinalysis showed negative. He prescribed me antibiotics anyway which I will take and I will guarantee you all my back pain will be gone, yet again. I would highly recommend you find another Dr. who will listen to you. I just read an article that said, “One study found a large fraction of fastidious and anaerobic bacteria (22.43%) was not detected under culture conditions, but only by using PCR.” I found out today that there are specialists called urogynecologists. That might be a good bet.
Good luck!
Funny, PCR is used in Ukraine to test bacteria. Poor Ukraine has better diagnostics than USA. I ended up treating my chronic kidney infection with herbs and oils. Oregano oil works taken internally. Basically you need to kill the bacteria. Mine became resistant to antibiotics but never ever got diagnosed by any doctors. It has been 3 years since I had my first acute kidney infection. I have come a long way. I educated myself on the subject well. I do not trust doctors anymore. I probably would have died or been on dialysis right now if I listened to them. their motive is profit and not my well being. Try natural remedies like oils. Oils are very strong but you will not develop resistance. Also I read this book called Natural Antibiotics and I used that info to help myself. It works.
Take care,
Inna
look up i.c.
It could be cystitis. I had it for yrs. Go to a different PCP and go to a Urologist. Good luck ! Its horrible.
Heather this is a follow-up to your above notation. I am interested in how you have been feeling, the past two years?
I felt sympathetic, to your situation. I am interested if you followed with a urologist? Did you have any other tests
done?
I am in similar situation with my mom, who is 90. She is an full-time care giver. My mom has been treated for 12
bladder infections or uti for 3 years. She has seen her primary care, with no results. Like you she wakes up about
four am. Can not get back to sleep. She has been having spasms, when she urinates. She falls asleep at the table at meal time. She gets up in middle of the night, to go the bathroom. nothing is released. She has low abdomen pain.
Her test come back positive. She goes on antibiotic, works a few, then it is back. Appt made with urologist.
Next appt opening, 3 moths to date. My mom is a nurse. She is very scared of whats going on inside of her.
Thank You for reading this.
Hi, wanted to reply to let you know i am in the same boat. im a 23 y.o. male, and i know it is predominantly women here. i have the same thing, constant urge to pee, constant bladder pain and burning in urethra. ive had it for 4 years. urine cultures always come back negative. have seen urologist who was useless. had a cystoscopy which was painful and turned up nothing. had an ultrasound as well. my girlfriend says my urine smells like hers did when she had a UTI. so i feel like i must have a UTI, but the doctors cant identify it! i feel like im going crazy but i just want to be rid of it.
same thing has happen to me… listen go online get cipro. get over the counter azo for uti .. doctors don’t realize tests 85 present come out negative when there is a infection!!!!!
I have been suffering from kidney infection that became chronic for 3 years. It ruined my life and my career. However every time a lab tests my urine, it comes back negative. Someone, please help me. I treated myself with Cipro when I got it first. It was kidney infection to begin with, no UTI. The infection returned after a month, I took Cipro again due to lack of insurance. The infection came back third time and I took Cipro again. Now I am resistant to Cipro, not sure what else left. Every doctor I go to says that it is all in my head and I am in perfect health. I have morning nausea, chills, fatigue, lack of appetite and lower back pain and nasty stinky night sweats. When I tell doctors, they do not even listen, they just look at the urine culture test and it is negative. I really need help, please. I do not want to lose my kidneys. I have insurance now but it does not help since the doctors will not even listen to me.
Inna
My heart went out to you when I read your post. I had a 6-month kidney infection in the UK a few years ago. The doctors and the hospital just kept sending me away with antibiotics and I was just so horrendously ill. I was off work for six months. I now live in Australia, and I had a another bad one last year. However, as soon as I rocked up at the hospital they took me straight in and placed me on intravenous antibiotics and I didn’t have to suffer again like I did in the UK. They were fantastic. They did a urinary test at the hospital and it was negative (as I was on antibiotics), and not long after they administered the intravenous antibiotics my blood pressure dropped considerably (as it was so high with being so ill) and my heart rate dropped to a healthy level.
I have another one at the moment but it’s “mild” compared to the others. I fell ill in work last week and felt horrendous; thought I was gonna die!! I had a temperature, my blood pressure was high and my pulse was racing; all sure signs of a kidney infection. Within 8 hours the antibiotics started to work, and burning and squeezing pain in my kidney started to lift. Yet the urine sample that was tested grew nothing.
As ever, one lot of antibis is never enough and I had to go back to see another out of hours doctor today as I could still tell the infection was there, and there was a slight trace of protein, so he’s given me a different lot of antibiotics and I can feel them
Can you take a different antibiotic? Or a lower dose over a longer period of time? Have you tried to get an appointment with a urologist? They’re usually very good, very thorough, even if your everyday doctors won’t listen to you.
Let me know how you’re getting on.
Gladwysstreet. Its good to know we are not alone sometimes. Im going through months of bladder and kidney infections. Ive been hospitalised 4 times already and the drs no longer belueve me. They say its impossible to have bladder.kidney infection every month and give me no antibiotic…
I fear the kidney ones bcuz they make u feel soo sick. Did you find answers?
Get a urine culture and sensitivity test. Do not just take cipro it is so strong has many side effect I know your desperate, I know what that feels like…First they must identify the specimen before they can kill it two tests thst were collected were invalid because of contamination. Go to urgent care and get antibiotics.or go to, Any Lab test Now pay them for the test you do Not need a doctor to order the test but you will get results. They have them here in our city , how easy and convenient no waiting around suffering quietly in pain . Next tell your MD to give you a referral to a kidney speacialist, nephrologist.
. My ND began to argue with my MD about my lab results I had ecoli in my urine the MD prescribed something strong, and the ND prescribed something else it was crazy. The MD did not want to believe the ecoli urinary result because it wasn’t cultured. I just wanted to get well . Ladies we need to be assertive and get taken care of , don’t be brushed off when your suffering and in pain get help even if you have to go to free clinic
Take D mannouse, get with a nautropathic who will help you learn was to keep the infection away.
Just an update on my post from earlyOctober…..Have still not been 100% and believe have also come down with a virus type glandular fever….still having recurring urination problems that seem to disappear for few days then comes back…have used a lot of DMannose which I think does help although costly…still trying to work out the right dosage and after sex, although this has not been very frequent last few months as I have been so uncomfortable…which of course is causing problems with my husband.
Have had 2 ultrasounds which result did not show much and now seeing a Urologist next week…maybe might get some light on this debilitating episode.
Cilantro (eat lots of it.) fresh from the produce & chase with lots of water. I mean a lot.
It has been awhile. How are you doing now?
I go through the samething.
I’ve been told by my gynecologist and Urologist that Cipro is resistant to about 30% of E. Coli bacteria, meaning, if you have certain strains, it won’t kill the bacteria. Nirtrofurantoin is 99% effective with treating E. Coli bacteria, which is what most bladder infections/UTI’s are caused by. I’ve had about 10 infections over the course of about 4 years. I was treated with cipro all of those times, except the last 2 infections I’ve had. If cipro is used to treat the infection and doesn’t completely kill the bacteria, it can lie dormant in the system and only needs a little bit of a trigger to flare up again. I would consider trying Nitro for treatment, if the doctor/specialist is willing to give it to you to try. It’s almost side effect free, as well. It’s good for generally healthy females who have recurring infections. I’m certainly not a doctor, but I’ve seen MANY MANY doctors over the course of the 4 years of being afflicted with these recurring infections and I’ve done my best to become educated about antibiotics, ureter function and potential harm, kidney function, and a lot about the whole pelvic floor system. Having researched all those things, I think it’s been helpful to me to know about things so I don’t panic and start taking antibiotics on my own, which I can become immune to if taken while there’s no infection. I hope this helps somebody!
Thank you for this insight. I am 34 weeks pregnant and was just hospitalized a month ago for a bladder and kidney infection and the culture came back negative the doctor sent another one at my follow up appointment. It too came back negative. When I went to the doctors office today for the symptoms of a bladder and kidney infection my urine read high levels of the infection but my culture was again negative so my doctor did not treat. I do not want to end up in the hospital again so I’m glad to read this information and will be contacting my doctor shortly about figuring a solution.
I just went to er the other day for uti symtoms. My blatter really hurt. I was having blatter spasms I took five pills of cipro I hhad left. The doc checked my urine and said it was perfect. No infection and no white blood cells in my urine. Im tired and was in pain. she would not give me antibiotics. Its been 2 days sense I went and pain has let up but still feel twinges. It doesnt burn to pee but mt blatter hurts when it is full. I took azo and it helped. I also had a pelvic exam for stds and they said everything looks great. Im still tired. I need to get back to work. I cant do this anymore. Is it possible I could have strained my blatter muscle
I have the exact symptoms and problem you have mentioned. How did this end up for you? I just don’t know what to do I have been taking antibiotics for a week now, in constant pain, and they found no bacteria. Any insight would be greatly appreciated.
I had the same thing. I found out that using body wash and bubble bath can irritate the bladder. So it is inflamed. It went away in time. But now I don’t take baths or don’t use bubble bath or body washes. I stay away from cipro, levraquen, or floxitines. I don’t take antibiotics unless I know I have an infection and won’t take those. There are black box warnings on them. Could make your body worse off for years to come. I wouldn’t take them unless I was on my death bed. Hope this helps.
hi I saw your post how are you feeling ? I am going trough the same thing as you
it appears to me that your urine was perfect because it was tested after you took antibiotics. You didn’t take them long enough however and the infection came back
Is this applicable to children?